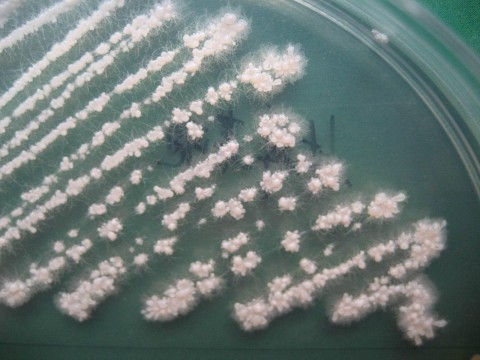
芽孢杆菌属

蜡样芽孢杆菌菌落

蜡样芽孢杆菌的菌落形态不典型,能排除吗?
图片尺寸1600x1200
蜡状芽孢杆菌的介绍
图片尺寸3264x2448芽孢杆菌美丽的菌落
图片尺寸1200x795
蜡样芽胞杆菌
图片尺寸2896x5152
微生物.忽然觉得微生物好像也挺好玩的,今日份的蜡样芽孢杆菌# - 抖音
图片尺寸1440x1458
芽孢杆菌菌落形态急急急
图片尺寸675x900芽孢杆菌美丽的菌落
图片尺寸1200x795一日一菌蜡样芽孢杆菌
图片尺寸1080x810
采用快速显色培养基检测蜡样芽孢杆菌更具优势
图片尺寸866x650
蜡样芽胞杆菌
图片尺寸5152x2896蜡样芽孢杆菌
图片尺寸1080x1080
蜡状芽孢杆菌
图片尺寸268x278
蜡状芽孢杆菌
图片尺寸859x966
蜡样芽孢杆菌
图片尺寸392x328
蜡样芽胞杆菌
图片尺寸2896x5152
下面的菌落是蜡样芽孢杆菌吗?
图片尺寸800x600
如枯草芽孢杆菌,炭疽芽孢杆菌,蜡状芽孢杆菌的芽孢位于菌体中央,卵
图片尺寸768x576
食物中毒原因-蜡样芽孢杆菌,仙人掌杆菌肠毒素介绍和检验
图片尺寸1920x806芽孢杆菌属
图片尺寸480x360
蜡样芽孢杆菌
图片尺寸600x372
猜你喜欢:蜡样芽孢杆菌枯草芽孢杆菌菌落蜡样芽孢杆菌片蜡样芽孢杆菌活菌胶囊贝莱斯芽孢杆菌芽孢杆菌凝结芽孢杆菌凝结芽孢杆菌活菌片巨大芽孢杆菌炭疽芽孢杆菌多粘类芽孢杆菌芽孢杆菌图片苏云金芽孢杆菌地衣芽孢杆菌解淀粉芽孢杆菌地衣芽孢杆菌活菌颗粒纳豆芽孢杆菌大肠杆菌菌落地衣芽孢杆菌活菌胶囊炭疽芽孢杆菌图片芽孢杆菌图片显微镜地衣芽孢杆菌胶囊苏云金芽孢杆菌图片炭疽芽孢杆菌革兰染色放线菌菌落放线菌菌落特征细菌菌落细菌菌落特征放线菌菌落图片酵母菌菌落特征格列佛游记小人国插图盐菜是什么菜爱的思念的简谱日本水俣病事件 丧尸深情的吻唱谱祈求图片头像做笔记 干净柯蓝老公47岁库班资产男士内裤的叠法北京张建设妙善公主出生地